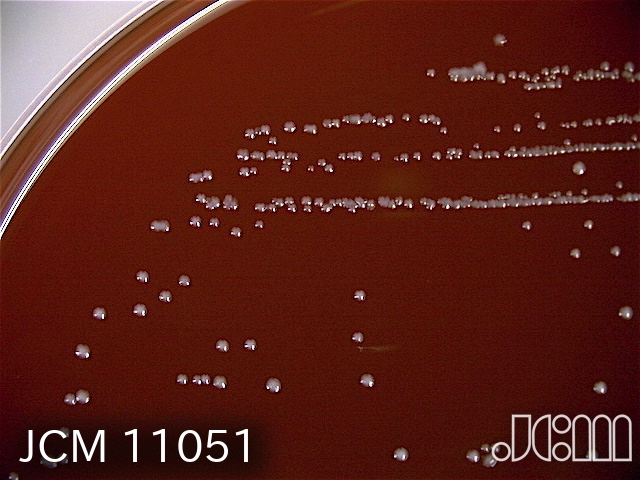

Limosilactobacillus pontis
DSM 8475
BACTERIA
How to read the following data (Example)
Name:
Limosilactobacillus pontis (Vogel et al. 1994) Zheng et al. 2020
DSM No.:
8475, Type strain
Strain designation:
LTH 2587
Other collection no.
or WDCM no.:
ATCC 51518,LMG 14187,JCM 11051
Isolated from:
rye sourdough
Country:
Germany
Germany, Stuttgart
Date of sampling:
before 30.08.1993
Nagoya Protocol Restrictions:
There are NO known Nagoya Protocol restrictions for this strain.
History:
<- P. Stolz <- G. Böcker, LTH 2587
Genbank accession numbers:
16S rRNA gene: X76329
whole genome shotgun sequence: AZGO00000000
Cultivation conditions:
Medium 638 , 30°C
Complete DSMZ Media List
Summary and
additional information:
<- P. Stolz <- G. Böcker, LTH 2587. Rye sourdough; Germany. Type strain. Taxonomy/description (5085, 38511). Sequence accession no. 16S rRNA gene: X76329, whole genome shotgun sequence: AZGO00000000. Murein: A21.4 (5085). (Medium 638, 30°C).
Literature:
5085, 38511
Risk group:
1 (classification according to German TRBA)
DSM8475